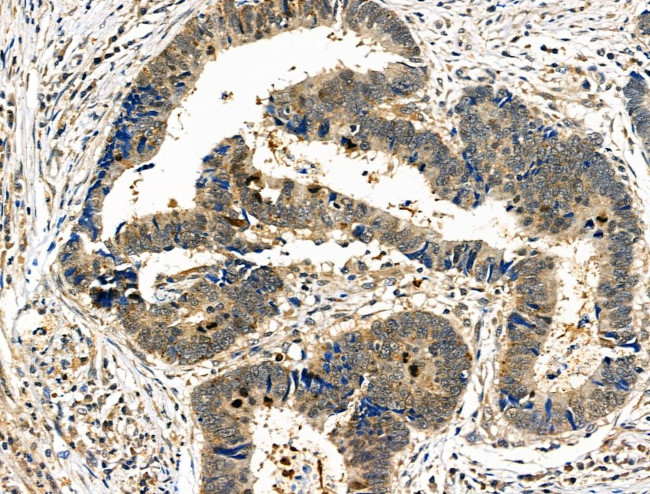
Phospho-PAK4/6/7 (Ser474) Antibody in Immunohistochemistry (Paraffin) (IHC (P))

Search
Invitrogen
Phospho-PAK4/6/7 (Ser474) Polyclonal Antibody
{{$productOrderCtrl.translations['antibody.pdp.commerceCard.promotion.promotions']}}
{{$productOrderCtrl.translations['antibody.pdp.commerceCard.promotion.viewpromo']}}
{{$productOrderCtrl.translations['antibody.pdp.commerceCard.promotion.promocode']}}: {{promo.promoCode}} {{promo.promoTitle}} {{promo.promoDescription}}. {{$productOrderCtrl.translations['antibody.pdp.commerceCard.promotion.learnmore']}}
图: 1 / 3
Phospho-PAK4/6/7 (Ser474) Antibody (PA5-114615) in IHC (P)



Please note: We are reviewing Western blot images included in the antibody testing data in our catalog, including those provided by third parties. Unless expressly labeled or annotated as “raw-unedited”, Western blot images included in the antibody testing data in our catalog may have been edited, optimized or otherwise adjusted for presentation.
产品信息
PA5-114615
种属反应
宿主/亚型
分类
类型
抗原
偶联物
形式
浓度
规格
纯化类型
保存液
内含物
保存条件
运输条件
RRID
产品详细信息
Antibody detects endogenous levels of PAK4/5/6 only when phosphorylated at Ser474.
靶标信息
PAK4 is highly expressed in prostate, testis and colon. PAK4 interacts tightly with GTP-bound but not GDP-bound CDC42 and weakly with RAC. PAK4 phosphorylates and autophosphorylates and also activates the JNK pathway. PAK5, a member of the PAK family of protein kinases contains a CDC42/Rac1 interactive binding (CRIB) motif at the N-terminus and a Ste20-like kinase domain at the C-terminus. PAK5 preferentially binds to CDC42 in the presence of GTP and the CRIB motif is essential for this interaction. PAK6 protein cotranslocates into the nucleus with androgen receptor, which is a steroid hormone-dependent transcription factor that is important for male sexual differentiation and development, in response to androgen. PAK6 was initially identified as an androgen receptor in a yeast two hybrid screen and was found to be highly expressed in testis and prostate tissues. Later experiments have shown it to be activated by MAP kinase 6 and p38 MAP kinase, suggesting that PAK6 may play a role in the cellular response to stress-related signals.
仅用于科研。不用于诊断过程。未经明确授权不得转售。
篇参考文献 (0)
生物信息学
蛋白别名: p21 (CDKN1A)-activated kinase 4; p21 (CDKN1A)-activated kinase 6; p21 (CDKN1A)-activated kinase 7; p21-activated kinase 4; p21-activated kinase 5; p21-activated kinase 6; p21-activated kinase 7; PAK 4/5/6; PAK 4/6/7; PAK-4; PAK-5; PAK-6; PAK-7; PAK4/5/6; Serine/threonine-protein kinase PAK 4; Serine/threonine-protein kinase PAK 5; Serine/threonine-protein kinase PAK 6; serine/threonine-protein kinase PAK 7
基因别名: 2900083L08Rik; 4732456M09; 5730488L07Rik; 6430627N20; AW555722; KIAA1142; KIAA1264; mKIAA1142; PAK-5; PAK-7; PAK4; PAK5; PAK6; PAK7
UniProt ID: (Mouse) Q8BTW9, (Mouse) Q3ULB5, (Rat) D4A280, (Mouse) Q8C015
Entrez Gene ID: (Mouse) 70584, (Rat) 292756, (Mouse) 214230, (Rat) 296078, (Rat) 311450, (Mouse) 241656